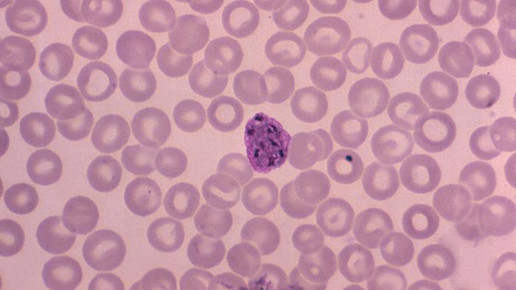

Malaria: Impfstoff erhöht Infektionsrisiko
Rückschlag im Kampf gegen Malaria: Der Impfstoff Mosquirix (RTS,S) von GlaxoSmithKline (GSK) erhöht womöglich nach einem initialen Schutz sogar das Infektionsrisiko. Dies berichten Forscher aus Kenia. Auf der Grundlage der Ergebnisse soll über die Aufnahme ins staatliche Impfprogramm entschieden werden.
Die Forscher hatten knapp 450 Kinder im Alter von 5 bis 17 Monaten entweder mit Mosquirix oder einer Vakzine gegen Tollwut geimpft. Je drei Impfdosen wurden verabreicht. Anschließend wurden die Probanden sieben Jahre lang beobachtet. Primärer Endpunkt war das Auftreten klinischer Malaria.
Im Beobachtungszeitraum traten insgesamt 1002 Malariaepisoden in der Mosquirix- und 992 in der Kontrollgruppe auf. Während im ersten Jahr 36 Prozent der Kinder gegen Malaria geschützt waren, sank die Wirkung im vierten Jahr auf Null. Danach waren die Kinder sogar weniger geschützt als die Probanden aus der Vergleichsgruppe: Das Risiko lag um bis zu 28 Prozent höher. In der Subgruppe der Kinder mit hoher Exposition in Malariagebieten war der Effekt sogar noch ausgeprägter.
Der Malaria-Rebound ist den Wissenschaftlern zufolge bereits in früheren Arbeiten beschrieben worden. Sie verweisen darauf, dass die Vakzine nur gegen Blutschizonten wirkt, nicht aber gegen andere Stadien, die der Erreger durchläuft. Sei sei es möglicherweise zu erklären, dass die Geimpften – anders als Erkrankte – keine Antikörper produzierten. Die Ergebnisse der Studie wurden im „New England Journal of Medicine“ veröffentlicht.
Die Europäische Arzneimittelagentur (EMA) hatte Mosquirix im vergangenen Jahr für den Schutz von besonders gefährdeten Kindern positiv bewertet – obwohl die Wirksamkeit begrenzt ist. Nach Angaben der Behörde überwiegen aber die Vorteile des Impfstoffs die Risiken. Eine mehrjährige Studie an 15.500 Säuglingen und Kleinkindern in Afrika hatte ergeben, dass Mosquirix in einem Zeitraum von bis zu vier Jahren einen Impfschutz von 26 bis 36 Prozent bietet.
Der neue Impfstoff sollte nach Herstellerangaben Kindern vier Mal verabreicht werden. Experten, auch von der WHO, kritisieren dieses Schema als zu aufwendig für arme, abgelegene Regionen. In Studien sollte der Impfstoff nun weiter getestet werden.
Mosquirix war von GSK mit Unterstützung der Bill & Melinda Gates Stiftung entwickelt worden. Der Pharmakonzern hat sich laut eigener Aussagen dazu verpflichtet, den Preis für RTS,S so festzulegen, dass die Herstellungskosten gedeckt sind und einen Gewinn von etwa 5 Prozent abwirft.

APOTHEKE ADHOC Debatte